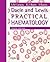
Dacie and Lewis Practical H...

S. Mitchell Lewis

|
Dacie and Lewis Practical Haematology
by
—
published
2011
—
12 editions
|
|

|
Practical Haematology
by
—
published
1975
—
16 editions
|
|

|
Postgraduate Haematology
by
—
published
1989
—
23 editions
|
|
|
Dacie and Lewis Practical Haematology: Expert Consult: Online and Print
by
—
published
2006
—
5 editions
|
|

|
Dacie and Lewis's Practical Haematology
—
published
2001
|
|

|
Dyserythropoiesis
by
—
published
1977
—
2 editions
|
|

|
Hematología práctica
—
published
2007
|
|

|
E-Book - Dacie and Lewis Practical Haematology: Expert Consult: Online and Print
|
|

|
Biopsy Pathology of Bone and Bone Marrow (Biopsy Pathology Series)
by
—
published
1985
|
|

|
Beckenkammbiopsien: Klinisch Interpretiert
by
—
published
1987
—
2 editions
|
|
Is this you? Let us know. If not, help out and invite S. to Goodreads.





